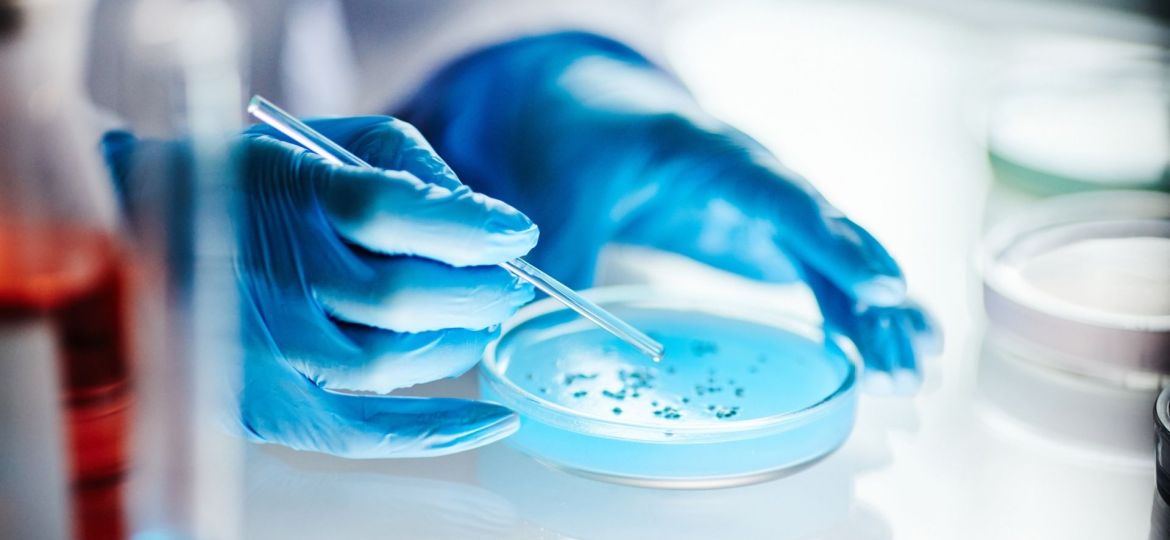
amibas na água

Os investigadores ambientais e de saúde pública estão a chamar a atenção para um grupo pouco conhecido de agentes patogénicos que pode representar um perigo global crescente: as amibas de vida livre. Num novo artigo, publicado na revista Biocontaminant, a equipa explica que estes organismos microscópicos estão a disseminar-se pelo mundo, impulsionados pelas alterações climáticas, pela deterioração dos sistemas hídricos e pelos esforços limitados de monitorização e deteção.
As amibas são organismos unicelulares que ocorrem naturalmente no solo e na água. A maioria é inofensiva, mas certas espécies podem causar doenças graves e, por vezes, fatais. Um dos exemplos mais conhecidos é a Naegleria fowleri (frequentemente chamada de amiba devoradora de cérebros), que pode causar uma infeção cerebral rara, mas quase sempre fatal. A infeção pode ocorrer quando a água contaminada entra pelo nariz durante atividades como a natação.
Porque é que estas amibas são tão difíceis de controlar?
“O que torna estes organismos particularmente perigosos é a sua capacidade de sobreviver a condições que matam muitos outros micróbios”, explica o autor correspondente Longfei Shu, da Universidade Sun Yat-sen, na China. “Podem tolerar altas temperaturas, desinfetantes fortes como o cloro e até viver dentro de sistemas de distribuição de água que as pessoas consideram seguros.”
Os investigadores salientam ainda que as amibas podem atuar como hospedeiras protetoras para outros micróbios causadores de doenças: as bactérias e os vírus podem sobreviver no interior das amibas, protegidos dos processos de desinfeção que normalmente os eliminariam. Este efeito, chamado ‘cavalo de Troia’, permite que os agentes patogénicos nocivos persistam e se propaguem pelos sistemas de água potável, podendo também desempenhar um papel no aumento da resistência aos antibióticos.
Estima-se que o aumento das temperaturas globais agrave o problema, permitindo que as amibas termofílicas se espalhem para regiões onde antes eram incomuns. Vários surtos recentes ligados à exposição à água de recreio já aumentaram a preocupação pública em vários países.
Um apelo a uma resposta integrada de One Health (Uma Saúde)
Os autores defendem uma estratégia coordenada de One Health que reúna a saúde pública, a investigação ambiental e a gestão dos recursos hídricos. Realçam a necessidade de uma melhor vigilância, de ferramentas de diagnóstico mais rápidas e precisas e de tecnologias avançadas de tratamento de água para reduzir os riscos antes que as infeções ocorram.
“As amibas não são apenas uma questão médica ou ambiental”, refere Shu. “Estão na interseção de ambas, e lidar com elas exige soluções integradas que protejam a saúde pública na sua origem.”
Crédito imagem: iStock















